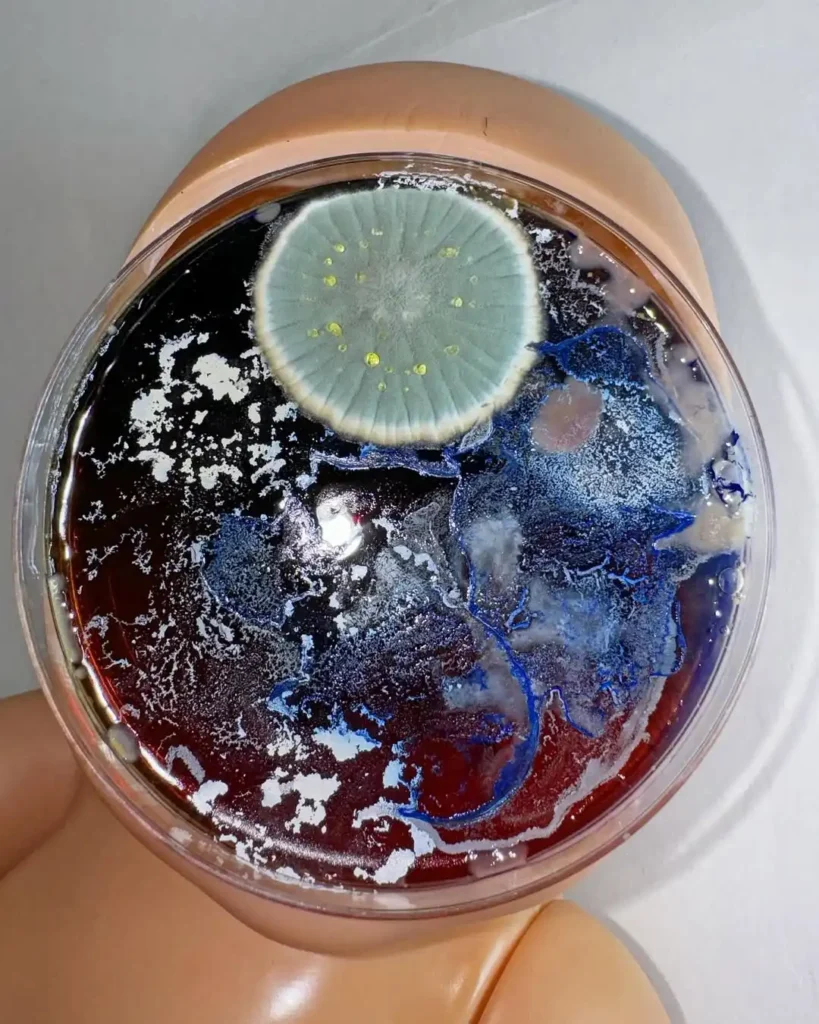

It was almost more than 7 years ago, when I was on Foundation course of Fine Art. We had a task to think about further practice, artist statement, etc, and due to my passion for lab aesthetics, science, surgery and similar, I got this idea of microbial depicting our world, using growing organisms, in the same way as oil paints or other traditional art mediums.
The way how they grow and communicate, while developing/ I can’t control their DNA, but I can make it more visible, more variable, while manipulating with lightning, additional supplements, stencils, vibrations, recipes and proportions. So it’s like an incubator for new textures, reactions, shapes and patterns. I can feel and see the whole purity and fascination of life there. With every artwork I feel more and more empowered, even if it’s contamination, because Nature is always showing me that organisms are just a part of it, not ruling ones. In other words this is a form of adoration of chaos and strict consciousness at the same time, formed into the form of a full cycle of art production. From the early beginning, when nothing is seen, to the finished object, for the brand campaign or prints on textile and museum grade interior prints.
Firstly I need to feel that I miss them and want to see them again. The way it’s possible is to let them grow, give this opportunity, through cooking the nutrient, adding pigments and initial spores. So I go to the kitchen and boil nutrient agar, before hardening I can affect the initial colours and artificial geometry, using stencils, tiny sculptures, stickers and so on. As soon as it’s a collaboration, I can do my part of the work as I want it to, and the rest is not my business, if we talk about one of my fav techniques of free seeding, when spores are just accidentally caught from the air.
I want the viewer to decide, because when you are adventuring through concepts and ideas, you want yourself also to be there. I have a very flexible concept, which could be both explored or abandoned by the audience. I would say in hashtags – power of the creator, nature, organical cycles, happy holyty of the death, beauty of different perceptions, outhere is a mirror of in there, diversity of material, infinitive rotation of creatures, power of conscious and the magic which comes when you are able to follow your heart.
Despite the pareidolia I can see some saint symbols growing, like crosses, or halos, forms of lettering and ornamentation, which could be seen as an echoes of ancient knowledge. I’m into spirituality, but can’t define myself as a super fanatic, I saw a lot of miracles around me. I know that this energy exists, and we are all starting to awaken for a bit, but it’s not a fast process. Vibrations of Love, Joy, Happiness, Belief, Gratitude are enormously powerful and healing. And without exception my art practice brings more value to it, from the side of personal experience and spiritual practices.
These guys are super talented and brave, when I first saw them I was so shocked like, wtf cmon this is amazingly inspiring. There is a lot of effort and hard work in their concepts, video production and items. I contacted them for the shooting, and we came up with the idea of growing mold on their iconic Seg shoes. That’s how it started. Experiments were super dramatic and in ongoing fail-to-success processes. I do not use antibiotics, thus there is a possible contamination, a lot of adrenaline and questions like : What if? Why not? Lets do this, fuck fear of unsuccess!
More dishes, experiments with conservation, textile printing, furniture, digitals, conceptual projects with institutions and brands, limited t-shirts drop, and more!